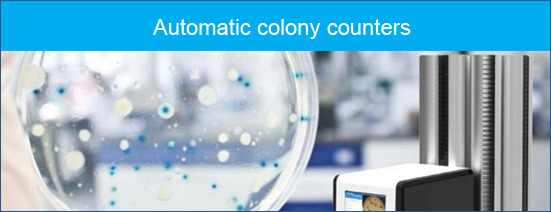

Rent a colony counter for your lab
Next to document scanners you can also rent a colony counter for your laboratory. The efficiency of laboratories
can and should improve. We were surprised to find out that many professional researchers are still operational with labour
intense processes. Laboratories can increase their output when they automate processes with
specialised plate count equipment.

Digitisation / automation in laboratories leads to:
- » higher productivity
- » better diagnosis
- » share knowledge
- » online knowledge sharing
- » better capacity utilisation for balancing supply & demand
Rent a colony counter
ScannerRent will gradually increase its' assortment on laboratory equipment for rent. Rental solutions at this very moment are only
possible for
colony counters. Rent an automatic colony counter to analyse your petri dish on bacteria. We offer a range of 4 colony
counter types taking into account:
- » Petri dish volumes: low volume / midrange / high volume colony counter analyses thousands of plates per day
- » Applications such as pour plate / spread plate / membrane filtration / spiral plate
- » Settings: region selection, colours, size, cluster analysis, impurities
All these colony counters are connected with a touch screen computer with analysis software and reporting modules. Easy to use
and easy to export results in .xls, .pdf or .doc.
Rent a colony counter and increase your lab productivity & lab performance.
Productinfo
Digitisation / automation in laboratories leads to:
Digitisation / automation in laboratories leads to: